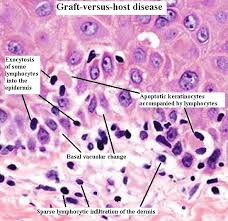

Cure rates impending seventy five percents can be achieved with combination chemotherapy, but this figure hide success rates that vary from ten to ninety percent with the different biological subtypes of the malady.
Nowadays, new insights into the underlying molecular biology of leukemia have changed our understanding of the disease. Not only are there a prospect of better treatment and the introduction of the new biologically based therapies, but, as the causes of disease are being unraveled, the possibility of prevention may not just be wishful thinking.
It has been recognized for a very long time that childhood leukemia is not one homogeneous disease. The main morphological division into acute lymphatic leukemia is supplemented by the identification of a range of subsets based on gene expression, antigens that delineate cell type or differentiation status, and chromosomal and molecular abnormalities.
There is now huge confirmation that chromosome trans location is very often the first event in infant twins with acute lymphocyte leukemia, the same breakpoints in the ML gene.
Further evidence that youth leukemia can originate before birth comes from scrutiny of neonatal blood spots or Guthrie cards. PR tests for specific fusion genes, designed for each patient, can detect as few as 1 in 20 leukemic cells in a blood spot. The presence of the same fusion gene sequence in a neonatal blood spot as is in the patient's leukemic cells at diagnosis provides unequivocal evidence that leukemia, has been initiated prenatally, probably by creation of the fusion gene itself.
If this form of leukemia progress is actually correct, it means that for every child with acute lymphocyte leukemia diagnosed, there should be at least twenty healthy children who have a chromosome trans location, a functional leukemia fusion gene, and a covert per-leukemic clone generated in-uteri.
Cord blood bank can help cure this disease thanks to the stem cells in the cord blood. The cord blood is simply the blood that remains in the placenta and umbilical cord after a baby is born and can be used because it is so rich in stem cells.
The stem cells found in cord blood restore the function of the patient's immune and blood producing systems, and is a powerful alternative to using bone marrow.
For Further Reading,